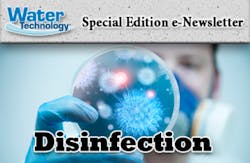
Disinfection-header_360x235.jpg Disinfection-header_360x235.jpg

Featured Articles
An overview of disinfecting water with popular technologies.
Three simple steps to ensure a safe drinking water supply when modern technologies are unavailable or inadequate.
Disinfectants can produce varying amounts and types of chemical byproducts that are considered contaminants.
UV light can safely remove many harmful microorganisms from drinking water.
Disinfection In The News
Recent news articles and press releases highlighting disinfection industry happenings.
Sponsor Content
UV Superstore’s enclosure will keep systems running efficiently for years with low maintenance.
Ozonation has emerged as one of the most effective and reliable solutions to removing micropollutants or emerging contaminants in aquatic environments.
UV Superstore’s UV lamps and quartz sleeves are manufactured in the U.S. and can be used in most UV systems.
As the leading vertical UV system manufacturer, OZONIA’s UV technology has proven its quality and reliability for over 25 years.
About the Author
Sign up for our eNewsletters
Get the latest news and updates